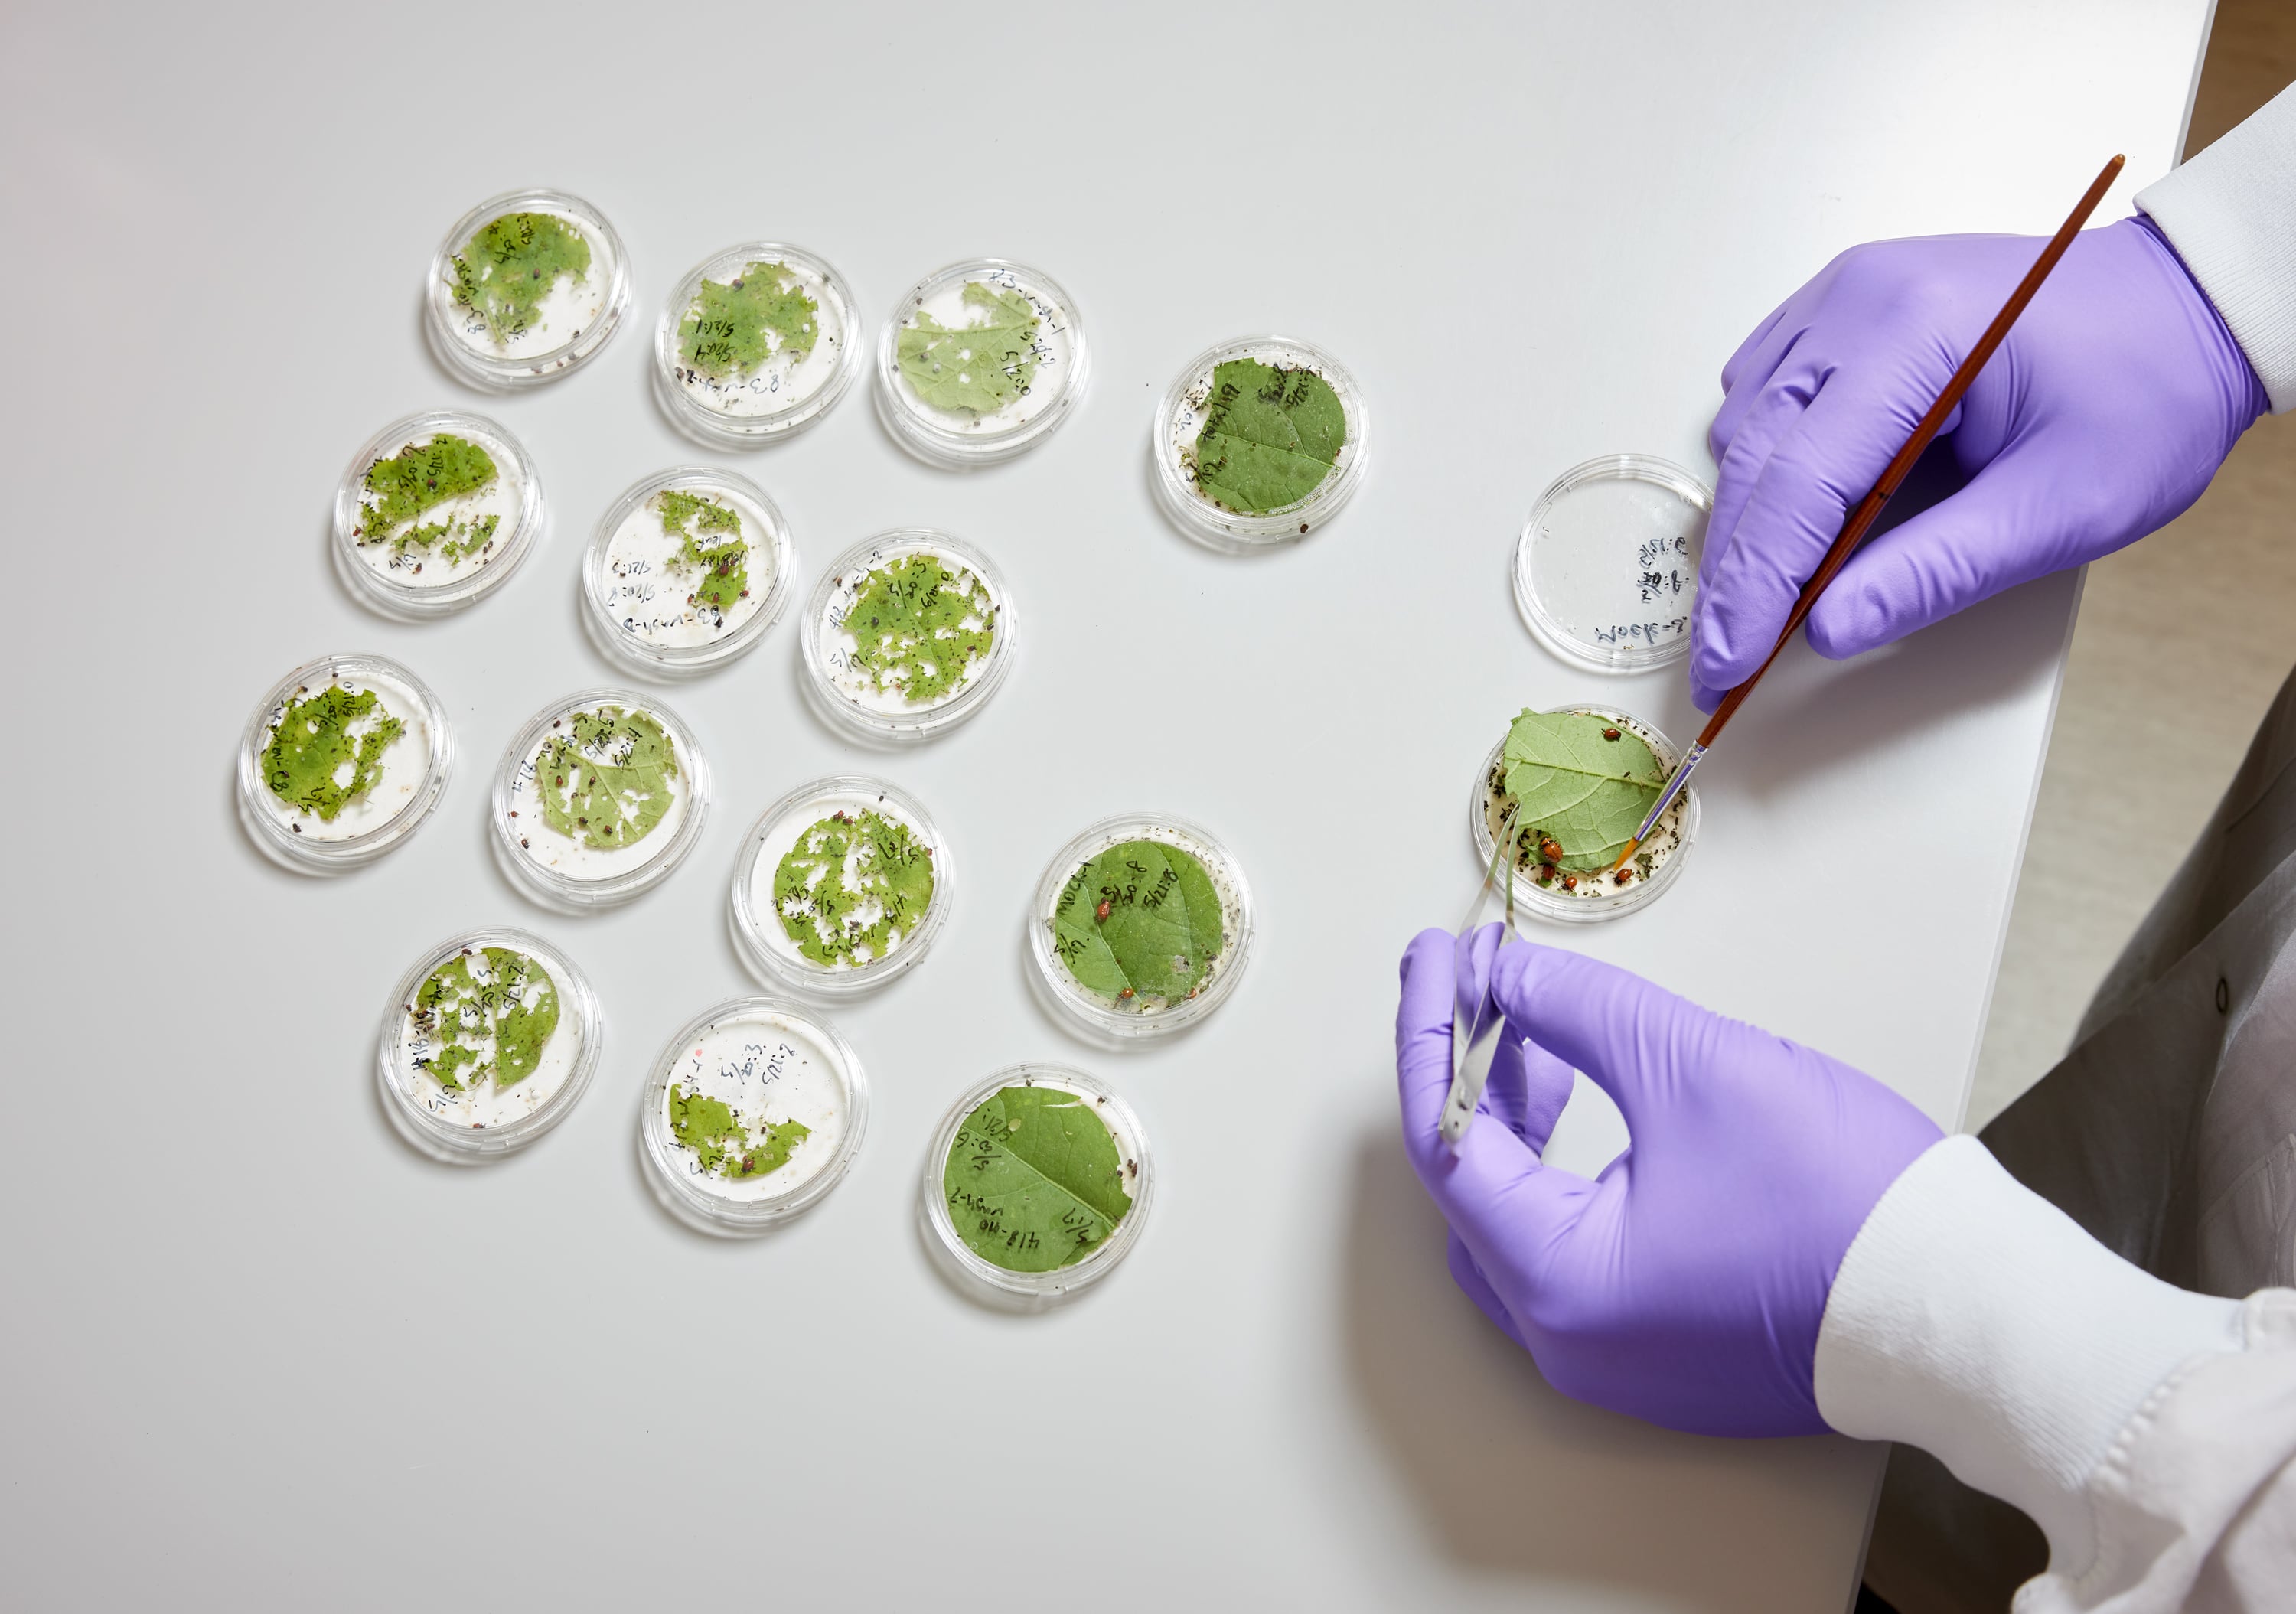
‘There are so many things we can do with this’... Terrana Biosciences to unleash RNA-based crop protection

‘Programmable plants’ to be created by British agri-biotech Azotic Technologies
Farmers could soon apply microbes to crops to ‘reprogram’ them to be resistant against pests, diseases and environmental stress such as drought and heat, as a new research project gets under way